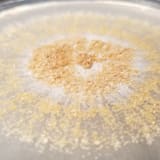

Maintenance
Commit Frequency
Further analysis of the maintenance status of mycotools based on released PyPI versions cadence, the repository activity, and other data points determined that its maintenance is Sustainable.
We found that mycotools demonstrates a positive version release cadence with at least one new version released in the past 12 months.
In the past month we didn't find any pull request activity or change in issues status has been detected for the GitHub repository.